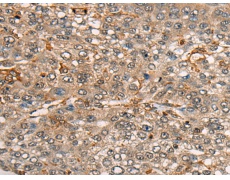
一抗

中文名稱: 兔抗CDT1多克隆抗體
別 名: DUP; RIS2
抗 原: CDT1
儲 存: 冷凍(-20℃)
宿 主: Rabbit
相關(guān)類別: 一抗
克隆類型: rabbit polyclonal
技術(shù)規(guī)格
|
Background: |
The protein encoded by this gene is involved in the formation of the pre-replication complex that is necessary for DNA replication. The encoded protein can bind geminin, which prevents replication and may function to prevent this protein from initiating replication at inappropriate origins. Phosphorylation of this protein by cyclin A-dependent kinases results in degradation of the protein. |
|
Applications: |
ELISA, WB, IHC |
|
Name of antibody: |
CDT1 |
|
Immunogen: |
Synthetic peptide of human CDT1 |
|
Full name: |
chromatin licensing and DNA replication factor 1 |
|
Synonyms: |
DUP; RIS2 |
|
SwissProt: |
Q9H211 |
|
ELISA Recommended dilution: |
5000-10000 |
|
IHC positive control: |
Human lung cancer and human liver cancer |
|
IHC Recommend dilution: |
30-150 |
|
WB Predicted band size: |
60 kDa |
|
WB Positive control: |
Human fetal brain tissue lysate |
|
WB Recommended dilution: |
500-2000 |

 購物車
購物車 幫助
幫助
 021-54845833/15800441009
021-54845833/15800441009